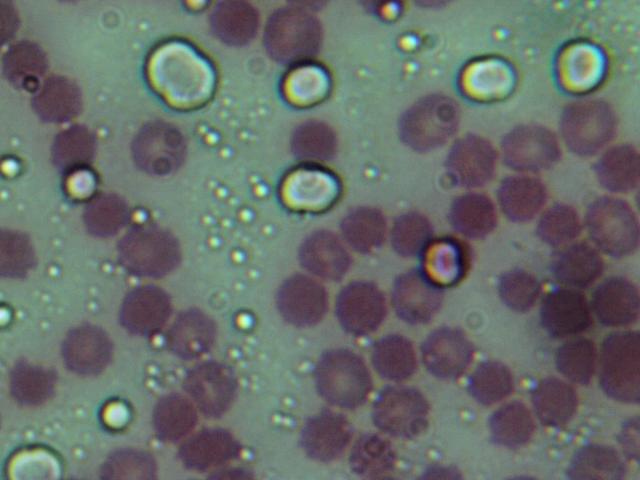

Week 3: September 16-20
Monday, September 16 (LS1-2): After making and recording corn seed observations, students plant seeds in soil in preparation for the next phase of our experiment.

Next, students will discuss the analysis questions from last Friday’s assignment. In The Breath of Life reading, students learned how the respiratory system of humans enables gas exchange, with the lungs inhaling oxygen and exhaling carbon dioxide. The gas exchange occurs within the alveoli, thin-walled sacs inside the lungs. The reading introduced the concept of feedback systems, focusing on the special nerve cells in the cardiovascular and nervous systems that can sense changes in pH. As carbon dioxide builds up, the blood becomes more acidic, and the lungs are forced to exhale to rid the body of carbon dioxide which then brings the pH back to normal levels.


For the last few minutes of class, we made a list of some of the ingredients found in tacos, and then categorized those food items as carbohydrates, proteins, or fats. We will dig into this work much more deeply tomorrow.

Tuesday, September 17 (LS1-2): After making and recording corn plant observations, students actively took notes and shared their understanding of biomolecules. Glucose is a simple sugar and the key ingredient in cellular respiration, the process organisms use to generate vast amounts of ATP energy. Sugars are one type of biomolecule. Our work today was to learn about three major classes of biomolecules: proteins, fats (lipids), and sugars (carbohydrates). We reviewed the monomers and polymers of each, and then students read pages 328-332 in our textbook and completed the associated worksheet. The assigned reading is titled Food: Our Body’s Source of Energy and Structural Materials. Now that students understand the link between photosynthesis (chemical potential energy stored in glucose), cellular respiration (glucose metabolized to transfer the energy in glucose to ATP), and the larger connection with the respiratory and cardiovascular systems, it is time to learn more about how the digestive system makes use of the variety of foods available to us. It is time to think beyond glucose.
Notes from class:



Wednesday, September 18 (LS1-2): After making and recording corn plant observations, we reviewed the reading from yesterday and focused in on an important group of enzymes responsible for digestion in the human digestive system. For the remainder of class, students worked with a partner on the Digestive System Gizmo activity packet.
Thursday, September 19 (LS1-2): After making and recording corn plant observations for the final time, students will work with a partner to complete the Digestive System Gizmo activity packet.
Friday, September 20: Students had the entire short Friday class period to work on the Digestive System Gizmo activity packet. Students were instructed to complete, at a minimum, through Activity B as homework before class on Monday.
Keep Learning!
Watch The Digestive System video by Mr. Anderson at Bozeman Science to learn more about this important area of study!

You must be logged in to post a comment.